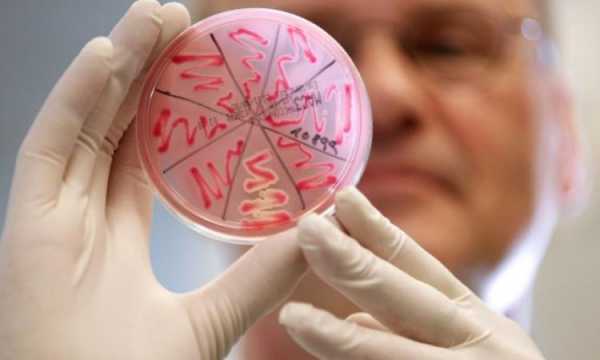

Симптомы прободной язвы желудка: стадии проявления и помощь
Возникновение сквозного повреждения желудочной стенки и вытекание внутреннего содержимого в соседние органы называется прободной (перфоративной) язвой. Это одно из самых тяжелых недугов брюшной полости. Основным условием для благоприятного исхода заболевания является своевременное оперативное вмешательство.
Начальные проявления прободной язвы желудка
Первые признаки перфорации стенки желудка зависят от клинической формы заболевания. Прободение может развиваться в следующих вариантах:
- типичная, когда желудочное содержимое сразу вытекает на 80-95% в брюшину;
- атипичная (прикрытая), когда прободение закрывается сальником или другим органом, находящимся рядом (вытекание составляет 5-9%).
Классической картиной патологии считается типичная форма перфорации. Первые симптомы прободения язвы желудка:
- усиление уже имеющихся у человека болей;
- тошнота, рвота;
- озноб;
- сухость во рту;
- слабость;
- сначала учащение частоты сердцебиения, а затем снижение;
- падение кровяного давления;
- кратковременная потеря сознания.

Стадия болевого шока
Дальнейшие признаки прободной язвы желудка пострадавшие сравнивают с ударом кинжала. Человек ощущает острую боль в брюшной полости, которая распространяется на верхние конечности. Малейшее прикосновение к любой части живота вызывает нестерпимый болевой синдром. В это время у пациента усиливается лихорадка, бледнеют кожные покровы, выступает холодный пот. Больной чувствует сильную жажду.
Скрытый период
Часов через 7 после острого периода яркие признаки прободения язвы желудка исчезают. У больного наступает облегчение, боли если и остаются, то незначительные. Симптомы скрытого периода:
- температура тела, пульс и артериальное давление приходят в норму;
- лицо приобретает нормальный оттенок;
- отсутствует обложенность и сухость языка;
- восстанавливается дыхание;
- при вытекании желудочного содержимого резкие боли стихают, но приобретают локализованный характер.

Перитонит
К концу первых суток после начала патологического процесса болезнь переходит в стадию разлитого перитонита. Боль снова становится нестерпимой, возвращаются тошнота и рвота, присоединяется икота. Основные симптомы прободной язвы желудка последней стадии:
- вздутый живот;
- температура тела до 38°С;
- психическая заторможенность;
- глаза западают внутрь;
- черты лица заостряются;
- кожа липкая, влажная, землистого цвета;
- уменьшается количество отделяемой мочи (вплоть до полного исчезновения).
Если игнорировать симптомы прободения или несвоевременно оказать помощь, то больной будет обречен на гибель. Летальный исход наступает уже на 2-3 сутки. Если операция будет проведена в течение первых часов после начала перфорации, то шансы пациента на полное выздоровления высоки.
Видео
Опрос Доверяете ли вы современной медицине?Спасибо за ответ Посмотреть результаты
Поделитесь с друзьями Ответить vrachmedik.ruПрободная язва желудка: симптомы
При отсутствии лечения эрозий на стенках желудка или гастрита болезнь переходит на сложный этап развития. Поставленный диагноз прободная язва несет тяжелые и смертельно опасные последствия. Заболевший человек рискует получить прободрение при нахождении язв на нежной поверхности желудочного мешочка либо на двенадцатиперстной кишке на протяжении месяца и более. Желудочный сок разрушающе воздействует на слизистые структуры и приводит к сквозной дыре на мышечных стенках желудка.

При помощи перфоративного отверстия в желудке жидкости для переваривания вытекают в брюшину, отчего организм подвергается воспалительному процессу и перитониту. Таким образом, прободную язву характеризуют, как появление просветов на стенках желудка либо двенадцатиперстной кишке по причине ухудшения состояния язвенной болезни.
Распространенность язвенного воспаления
Заболевание язвенной болячкой приходится чаще на взрослых людей от 30 до 50 лет. 10% людей на земном шаре поражены подобной болезнью. Чаще осложнение прободной язвой встречается в части дистального отдела желудочного мешочка либо на передней стенке двенадцатиперстной кишки.
Поражения и эффект прободрения язвы тоже возникают на пищеводе, толстой или же тонкой кишках . Появление дыр происходит, как при острой язвенной болезни, так и при хроническом, долгом течении заболевания. Проборации достигают до 10 сантиметров в диаметре, но чаще встречаются поражения не более 3-х сантиметров.
РЕЦЕПТ ПРОТИВ ГЛИСТОВ
Врачи выяснили, что является самым эффективным средством от глистов! По статистике, глисты есть у каждого 5 Россиянина. Читайте скорее рецепт, который поможет очистить организм от глистов всего за 7 дней…
Читать далее >>

По статистическим данным мужской организм в большей степени предрасположен к язвенной болезни. Следовательно, прободная язва желудка встречается у этой категории людей на 30% чаще. Причиной этого служит наличие в женском организме эстрогенов, которые не дают сильно выделять желудочный секрет на слизистой оболочке внутренних органов.
Прободная язва желудка, симптомы её проявления возникают по различным причинам. Наличие или отсутствие такого осложнения зависимо от профессионализма и внимательности врачей в больнице или поликлиннике при устранении язвенной болезни на начальной стадии. Сильное влияние оказывают климатические условия, окружающие человека и время года. Отягощение состояния болезни язвой и последующее возникновение прободной язвы преимущественно приходится на весну или же осень.
Часто встречающиеся случаи проявления заболевания:
- В основании двенадцатипёрстной кишки у мужчин от тридцати лет. В 90% случаев заболевшие люди до этого имели непродолжительный период лечения язвенной болезни. Но чем моложе пациент, тем больше вероятности внезапного возникновения язвенного прободрения. Прободная язва органов желудка или двенадцатиперстной кишки возникает у мужчин от 50 до 60 лет, которые уже давно имели заболевание хронической язвы с некоторыми периодами обострений.
- Статистика имеет обобщенный характер. Встречались ситуации, когда прободная язвочка проявлялась у маленьких детей, либо же у стариков. Причинами таких аномалий выступает неправильное питание и наследственная склонность к болезнями пищеварительной системы.

Известно, что лучшее лечение – это профилактика. С язвенной болезнью это лишний раз подтверждается. Соблюдение диетического питания и устранение из жизни вредных привычек позволяет людям минимизировать риск заболевания прободной язвы.
Основания для возникновения осложнения
При установлении язвенной болезни человек подвергается рискам появления прободной язвы. Факторами, влияющими на возникновения дыр в слизистых оболочках служат следующие действия:
- обострение диагноза язвы или гастрита;
- переедание и растяжение человеком стенок желудка;
- превышение кислотности желудочных выделений;
- несоблюдение диетического питания для язвенников;
- употребление алкогольных напитков;
- превышение привычной физической нагрузки на тело.
Такие причины, по которым возникает прободная язва относятся только к людям уже подверженным язвенной болезни. Факторы, влияющие на возникновение дыр, нарушают гармонию во внутренних органах, привнося дисбаланс защитной системы слизистых оболочек.

Защитная система слизистых в теле человека представляет собой:
- клетки эпителия, покрытые умеренным количеством слизи, вырабатываемой самой оболочкой;
- вещества бикарбонаты вырабатываемые в двенадцатиперстной кишке ;
- отсутствие чувствительности на некоторых соединительных тканях;
- порядок оснащения кровью желудочных стенок и отделов двенадцатиперстной кишки;
- гормональная подвижность слизистых оболочек. Стенки желудка способны вырабатывать гормоны гастрина, секретина, саматостатина;
- индивидуальная способность человеческого организма к регенерации тканей.
Современные медицинские исследования отмечают, что влияние на развитие воспалительных процессов оказывает бактерия Helicobacter pylori. Подтверждением служат проведённые опыты с принудительным обсеменением пациентов с болячками, как двенадцатиперстной кишки, так и желудка. После такого рода опытов больные получали курс антибактериальной терапии, который дал качественные результаты и устранил развитие болезни.
Но не только наличие в организме человека бактерии Helicobacter pylori способно повлиять на появление прободной язвы. Значение имеет общее состояние здоровья человека и его иммунная система. Факторы, которые влияют на возникновение прободной язвы:
- если человек был подвержен химиотерапии, тяжелым инфекционным заболеваниям или по другим причинам ослабил иммунную систему, то у него существует риск осложнения.
- если присутствовало заражение бактерией Helicobacter pylori;
- при нарушении режима сна и постоянных ночных сменах;
- в случае бесконтрольного употребление лекарственных средств противовоспалительного характера;
- при постоянном стрессовом состоянии и нервном перенапряжении;
- при никотиновой зависимости и злоупотреблении алкоголем;
- в случае предрасположенности, обусловленной наследственными особенностями;
- в случае неправильного режима и рациона питания. Преобладание в рационе острых, копченых продуктов, которые пережигают слизистые оболочки стенок желудка. При правильном питании пищу следует запивать жидкостью, чтобы излишне не нагружать желудок грубой пищей.
- при хронических заболеваниях желудка или же пищеварительной системы в целом.
Острая боль при развитии осложнения и открытии прободной язвы длится на протяжении трех-шести часов. В дальнейшем болезненные ощущения снижаются.

Разновидности осложнения
Исходя из того, что проявлений прободной язвы много, выделяют следующие виды данного осложнения:
Основываясь на происхождении болезни:
- прободрение язвы хронического вида;
- проявление дыр по причине обострения;
- возникновение опухоли в стенках внутренних органов;
- прободрение по причине заражения паразитами;
- дыры из-за нарушенной системы движения крови.
Локализация осложнения:
- Желудочные дыры. Прободная болячка возникает в передней и в задней частях желудка, в кардиальном, антральном, препилорическом, пилорическом отделах.
- Прободной абсцесс в двенадцатиперстной кишке. Подразделяются на категории бульбарной дыры и постбульбарной.

Беря в расчет клинические показатели:
- разрыв в полость брюшины;
- разрыв, производящийся в сальниковую сумку или сальники, забрюшинную клетчатку, в межспаечную область.
- разрыв, сопряжённый и кровяной активностью. Пищевые массы изливаются не только по области брюшины, но и в пищеварительную систему.
Основываясь на стадиях появления и роста осложнения:
- начальная стадия шокового состояния. Возникает во время развития химического перитонита.
- размножение бактерий и рост бактериальной формы перитонита;
- воспалительная форма перитонита;
- стадия гнойной формы перитонита и тяжелый сепсис.
Основанием для возникновения прободной язвы является наличие у пациента болезни гастритом или других нарушений структуры слизистой желудка.

Симптоматика язвенного осложнения
Первоначальные симптомы, свидетельствующие о прободной язве, возникают, когда человеческая пища начинает проникать в брюшную полость. Данный процесс разделяют на четко определенные стадии развития.
Начальный период характеризуется тем, что на протяжении 4-7 часов сквозь дыру на стенке желудка либо двенадцатиперстной кишки изливаются пищевые массы, которые вызывают перитонит полости брюшины. В случае с двенадцатиперстной кишкой, её содержимое может не вызывать воспалительного процесса на протяжении 12 часов.
При образования дыры и излития пищевых масс человек ощущает резкую боль, локализованную в эпигастральной части тела. Болевые ощущения настолько сильные и резкие, что их сравнивают с ножевым ранением либо же ожогом кипящей смолой.

Предугадать начало течения осложнения можно при возникновения боли в правой части предребья. Но такого рода симптом характерен, когда возникновение прободной язвы произошло в двенадцатиперстной кишке.
Для снижения болевых ощущения пациент стремится принять максимально комфортное положение. Чаще всего это подогнутые до груди ноги и в лежачем на боку положении.
Кроме болевых ощущений заболевший человек приобретает чрезмерно бледный оттенок кожи, снижается артериальное давление. Больной дышит грудью, его дыхание частое и поверхностное.
На брюшной полости присутствует несвойственное перенапряжение мышц живота, возникновение ладьевидного пресса. Пациенту тяжело проходить физический осмотр и пальпацию по причине сильных болевых симптомов. Симптомы перенапряжения мышц живота не видны у людей, находящихся в алкогольном опьянении, либо же у людей с излишними жировыми отложениями.
Вторая стадия характеризуется размножением бактерий в брюшной области. После того, как образовалась первая дыра и пищевые массы стали проникать в живот вторая стадия, наступает спустя шесть часов. Болевые ощущение снижаются, и пациент чувствует улучшение своего состояния. Однако, улучшение свидетельствует о присутствии сильнейшей интоксикации организма. Анализ крови пациента при таком состоянии показывает присутствие большого количества лейкоцитов. Также, у заболевшего человека увеличивается температура тела. Психологическое состояние пациента показывает то, что он уже не беспокоится о собственном здоровье и стремится только к тому, чтобы его оставили в покое.
Важным моментом будет являться то, что медицинская помощь должна быть оказана в эти первые два периода. Заболевшему человеку следует провести срочную операцию по устранению прободной язвы, а также по очищению от перитонита брюшной полости.
Третья стадия характеризуется стремительным ухудшением общего состояния здоровья. Обычно такая стадия наступает спустя 12 часов после возникновения первых симптомов и болей. Данная стадия свидетельствует о том, что человеческий организм уже получил огромную дозу токсических веществ. Первым симптомом того, что третья стадия наступила являются рвотные позывы. Рвота ведет к стремительному обезвоживанию тела больного, что в значительной степени ухудшает его состояние. Опасный третий этап характеризуется повышением температуры тела до 40 градусов. После чего возможно резкое снижение температуры до нормальных 36,6.

Живот пациента становится чрезмерно раздутым, область брюшины раздражена. На третьей стадии хирургическое вмешательство чаще всего оказывается малоэффективным. Пациента ожидает смертельный исход.
Диагностические показатели
Диагностику проводят следующими способами:
- Данные клинического исследования. Врач осматривает внешние признаки пациента. Основным является сильнейшая боль в области живота. Подтверждением перитонита прободной язвы могут выступать сведения в карте пациента о гастрите или же язвенной болезни. Далее, врач проводит пальпацию болезненных участков. Назначается рентгеновский снимок для внесения уточнения диагноза болезни. При помощи снимка врач определяет количество воздушного пространства в брюшине. Если при рентгеновском снимке присутствие перитонита не подтвердилась, однако признаки прободной язвы все равно имеются, назначается диагностика эндоскопом. Он позволяет определить в какой части желудка или же двенадцатиперстной кишки образовалась дыра. После процедуры эндоскопии может быть проведен дополнительный сеанс рентгеновского снимка.
- Исследование при помощи электрокардиограммы. Процедура необходима, чтобы установить состояние здоровья человеческого сердца.

- Информация, полученная с ЭКГ, дает возможность врачам определиться с анестезией для последующей операции. Данная процедура также помогает исключить клиническую форму инфаркта миокарда из вариантов заболевания.
- Диагностика осложнения при помощи аппарата УЗИ. Если у пациента обнаружена стандартная прободная язвочка, то узи никакой полезной информации для врача не предоставит. Но если имеется несколько перитонитов, которые отделены друг от друга спайками УЗИ помогает определить их точное местонахождение.
- Исследования лабораторным путем. При поступлении пациента в скорую помощь ему в срочном порядке делается развернутый анализ крови. Биохимический анализ помогает определить наличие или же отсутствие воспалительной реакции организма, исключить заболевание панкреатитом.
Процесс лечения прободной язвы
Как только пациент поступил с острыми болями в животе врач предупреждает его о возможности срочного хирургического вмешательства. При подтверждении диагноза прободной язвой только такой путь поможет пациенту сохранить жизнь.

Существует метод лечения, который не предполагает проведения операции. Данное лечение получило название метод Тейлора. Но подобный подход не надежен и имеет низкий уровень выживаемости больных.
Однако, до двадцатого века именно метод врача Тейлора имел достаточную распространённость во врачебной практике. В настоящее время он используется при невозможности провести экстренную операцию, либо же вы случае категорического отказа пациента от хирургического вмешательства.
Метод Тейлора предполагает:
- Введение в желудочный такт зонда, для освобождения его от скопившихся пищевых масс. Зонд нацелен на полное очищение желудка и дренаж внутренних органов на протяжении трех суток. Прикладывание к животу ледяных компрессов. терапия по нормализации показателей баланса кислотной среды, проведение процедур дезинтоксикации, после проведения процедуры дренажа. Курс приема антибиотиков.
- В процессе очищения желудка пациента по методу Тейлора, больному вводится контрастное вещество. Оно необходимо для подсвечивания содержимого брюшины на рентгеновском снимке. Такая подстраховка позволяет убедится врачам, что внутренние органы больного чисты.

Даже несмотря на удачно проведенную операцию по устранению прободной язвы риск возникновения заражений, гнойных перитонитов и других крайне высок в первую неделю после хирургического вмешательства.
Действенным методом является операция. После неё пациенту на всю жизнь придется отказаться от определённых категорий продуктов. Основу питания для него будут составлять вареная и диетическая пища.
Категорически запрещено к употреблению:
- алкоголь и сигареты;
- кофе;
- пряности, приправы;
- цитрусовые фрукты;
- шоколад;
- фасоль и горох;
- копчености и жаренные продукты.
Соблюдение строгой диеты – вот что поможет людям, больным язвенной болезнью предотвратить прободную язву.
vnutrizhivota.ru
Прободная язва желудка — симптомы, неотложная помощь, лечение
Прободная язва желудка – это такое сквозное повреждение, которое образуется на месте хронической или острой язвы. Чаще всего развивается у людей старше 40 лет, еще чаще – у пожилых. Представители мужского пола сталкиваются с представленным состоянием в 10 раз чаще, чем женщины. В среднем прободная язва желудка как осложнение основного заболевания формируется в двух случаях из 10000. Однако для того чтобы подобные перфоративные изменения были исключены, очень важно озаботиться определением их причин, симптомов и методов лечения.
Причины развития прободной язвы
К ведущим факторам риска представленного состояния следует причислить присутствие острого или хронического язвенного поражения желудка, а также диагностированную хеликобактерную инфекцию (у 60—70% от общего количества пациентов). В перечне более редких причин образования прободной язвы желудка находится не только дестабилизация деятельности желез внутренней секреции, но и:
- атеросклероз;
- недостаточность в рамках процесса кровообращения;
- тяжелые респираторные расстройства с формированием ишемии внутренних органов.
Прободная язва желудка традиционно ассоциируется с тремя последовательными стадиями. Первая из них продолжается до шести часов после прободения. На представленном этапе кислый сок из области желудка проникает в область брюшины, провоцируя существенное химическое повреждение данного участка. Сопровождается представленное состояние неожиданными интенсивными болезненными ощущениями в животе.
Вторая фаза возникновения прободной язвы (от шести до 12 часов с момента прободения) будет ассоциироваться с интенсивным производством экссудата. Именно он обеспечивает разбавление соляной кислоты, что с течением времени приводит к существенному снижению болей в животе у больного. В третьей фазе (от 12 до 24 часов с момента прободения) начинается развитие гнойного перитонита, вполне вероятным является формирование межкишечных абсцессов у больного. Все указанные физиологические состояния будут сопровождаться достаточно выраженными и узнаваемыми симптомами.
Симптомы состояния
Признаки прободной язвы заключаются в усилении болезненных ощущений в области желудка. Начинается это за несколько суток до перфорации. Далее хотелось бы отметить другие симптомы прободной язвы желудка:
- иррадиация болей напрямую зависит от локализации язвы: в руку (плечевую область и лопатку) справа при пилородуоденальной язве, слева – при размещении дефекта в области днища и тела желудка;
- при прорыве язвы задней стенки желудка определенное количество соляной кислоты будет изливаться в клетчатку пространства за брюшиной (или сумку сальника), а потому боли при перфорации практически не выражены;
- в процессе проведения осмотра обращает на себя внимание вынужденная поза с приведенными к области живота коленями, страдальческое выражение на лице;
- дополнительно проявляется существенное усиление болезненного синдрома при попытке осуществления каких-либо движений.
Поперечные борозды на прямых мышцах живота оказываются гораздо более выраженными, отмечается втягивание живота при осуществлении вдоха (так называемое парадоксальное дыхание). Артериальная гипотония будет ассоциироваться с брадикардией и даже одышкой. В течение первых часов с момента развития заболевания идентифицируется очевидная болезненность при пальпации непосредственно в эпигастрии. В будущем она будет распространяться на всю переднюю брюшную стенку.
Клинические проявления раздражения брюшины являются резко положительными. Однако, рассказывая о прободной язве желудка, симптомы которой очевидны, не следует забывать об основных диагностических мероприятиях, которые чрезвычайно важны перед началом восстановительного курса.
Как проводят диагностику язвы?
Всем пациентам с подозрением на представленное поражение желудка требуется максимально срочная консультация не только гастроэнтеролога, но и хирурга. Целью всех инструментальных исследований и консультаций является идентификация свободной жидкости и газа в брюшине, язвенных дефектов и перфоративного отверстия.
Обзорная рентгенография является информативной в 80% случаев, позволяя определить наличие свободного газа в брюшине. Для более точной постановки диагноза прибегают к КТ органов брюшной полости (не менее 98% информативности). Кроме того, УЗИ является одним из наиболее точных и доступных способов идентификации прикрытых перфораций. Эзофагогастродуоденоскопия позволяет определить диагноз прободной язвы желудка в 90 случаях из 100. Помимо этого, за счет фиброгастроскопии определяется оптимальная тактика в связи с хирургическим вмешательством при прободной язве желудка и при ее прободении.
Диагностическая лапароскопия является, пожалуй, наиболее восприимчивой методикой идентификации данного состояния, а также газов и выпота в свободной брюшине. Дифференцировать язву настоятельно рекомендуется с такими состояниями, как:
- острый аппендицит;
- холецистит;
- панкреатит;
- аневризма брюшной аорты;
- инфаркт миокарда.
Исключительно после этого можно говорить о том, каким должно быть лечение, в частности, неотложная помощь и послеоперационный период.
Коротко об оказании неотложной помощи
При идентификации прободной язвы желудка больного настоятельно рекомендуется поместить на щит или носилки. При этом у него обязательно должен быть приподнят верх туловища, а ноги согнуты в области коленных и тазобедренных суставов. Далее на область живота кладут что-либо холодное (лучше всего если это будет пузырь со льдом). Затем человека экстренно госпитализируют в хирургическое отделение, где неотложная помощь будет оказываться уже хирургами.
Особенности лечения
В хирургическом лечении специалисты обращают внимание на три основных подхода, а именно проведение закрытых перфораций, иссечение желудочной язвы и его резекцию. У подавляющего большинства пациентов проводится закрытие перфорации с применением тампонады (введение тампонов), прикрытия сальником или даже ушивания. Показаниями к проведению закрытия прободной язвы в области желудка следует считать бессимптомную перфорацию, продолжительность течения заболевания больше 12 часов. Также не следует забывать о наличии симптомов перитонита и крайне тяжелом состоянии больного.
Начало терапии позже, чем спустя 24 часа от перфорации, способно в три раза увеличить показатели летальности. Оптимизировать результаты вмешательства по закрытию данного состояния позволит антихеликобактерная и антисекреторная терапия после операции. Также оказывать на это положительное влияние может первая помощь, оказанная непосредственно хирургом или другим специалистом. Необходимо учитывать, что:
- примерно у 10% пациентов внедряются так называемые малоинвазивные методики хирургического вмешательства, например, лапароскопическое и эндоскопическое;
- применение лапароскопических операций дает возможность снизить частотность осложнений после хирургического вмешательства и даже показатели летальности;
- разные методики операций могут комбинироваться между собой (допустим, лапароскопические с эндоскопическими), а также с ваготомией.
Если во время процедур ваготомия не осуществлялась, то в периоде после операции назначается специальная противоязвенная терапия. Речь идет об использовании ингибиторов протонной помпы и блокаторов Н2-гистаминовых рецепторов, также допустимо применение антихеликобактерных лекарственных средств, что позволяет быстро исключить прободение язвы желудка.
Консервативная терапия
Консервативное лечение внедряется исключительно в двух ситуациях: при наличии декомпенсированного соматического патологического состояния и решительном отказе пациента от хирургического вмешательства. Условиями для обеспечения именно консервативной терапевтической тактики следует считать: меньше 12 часов с момента перфорации, возраст не больше 70 лет, отсутствие напряженного пневмоперитонеума и нормальная гемодинамика.
В комплексе такого лечения находится целый перечень мероприятий. Речь идет об обезболивании, использовании антибиотиков и антисекреторных наименований, осуществлении антихеликобактерной и дезинтоксикационной терапии. Далее хотелось бы обратить внимание на то, какими будут прогноз и профилактика, если у человека развилось такое положение.
Прогноз и профилактика прободной язвы
Прогноз при прободной желудочной язве будет зависеть от множества факторов. В частности, вероятность развития летального исхода в существенной мере увеличивается при возрастной категории больного более 65 лет и тяжелых сопутствующих патологиях. Речь идет об онкологических заболеваниях, СПИДе, цирротической трансформации печени. Другими факторами специалисты называют значительные размеры перфоративного отверстия, продолжительное течение прободной язвы желудка до хирургического вмешательства.
Необходимо учитывать, что не меньше 70% летальных исходов при язвенном заболевании желудка ассоциируются именно с прободной язвой. Единственно возможным профилактическим методом следует считать своевременную идентификацию и лечение язвенного заболевания желудка. Таким образом, симптомы и лечение состояния определены давно и при наличии каких-либо подозрений настоятельно рекомендуется обратиться к гастроэнтерологу.
КАК ЗНАЧИТЕЛЬНО СНИЗИТЬ РИСК ЗАБОЛЕТЬ РАКОМ?
Лимит времени: 0
ПРОЙДИТЕ БЕСПЛАТНЫЙ ТЕСТ! Благодаря развернутым ответам на все вопросы в конце теста, вы сможете в РАЗЫ СОКРАТИТЬ вероятность заболевания!
Вы уже проходили тест ранее. Вы не можете запустить его снова.
Тест загружается…
Вы должны войти или зарегистрироваться для того, чтобы начать тест.
Вы должны закончить следующие тесты, чтобы начать этот:
Время вышло
1.Можно ли предотвратить рак?
Возникновение такого заболевания, как рак, зависит от многих факторов. Обеспечить себе полную безопасность не может ни один человек. Но существенно снизить шансы появления злокачественной опухоли может каждый.2.Как влияет курение на развитие рака?
Абсолютно, категорически запретите себе курить. Эта истина уже всем надоела. Но отказ от курения снижает риск развития всех видов рака. С курением связывают 30% смертей от онкологических заболеваний. В России опухоли лёгких убивают больше людей, чем опухоли всех других органов.
Исключение табака из своей жизни — лучшая профилактика. Даже если курить не пачку в день, а только половину, риск рака лёгких уже снижается на 27%, как выяснила Американская медицинская ассоциация.3.Влияет ли лишний вес на развитие рака?
Почаще смотрите на весы! Лишние килограммы скажутся не только на талии. Американский институт исследований рака обнаружил, что ожирение провоцирует развитие опухолей пищевода, почек и желчного пузыря. Дело в том, что жировая ткань служит не только для сохранения запасов энергии, у неё есть ещё и секреторная функция: жир вырабатывает белки, которые влияют на развитие хронического воспалительного процесса в организме. А онкологические заболевания как раз появляются на фоне воспалений. В России 26% всех случаев онкологических заболеваний ВОЗ связывает с ожирением.4.Способствуют ли занятия спортом снижению риска рака?
Уделите тренировкам хотя бы полчаса в неделю. Спорт стоит на одной ступени с правильным питанием, когда речь идёт о профилактике онкологии. В США треть всех смертельных случаев связывают с тем, что больные не соблюдали никакой диеты и не уделяли внимания физкультуре. Американское онкологическое общество рекомендует тренироваться 150 минут в неделю в умеренном темпе или в два раза меньше, но активнее. Однако исследование, опубликованное в журнале Nutrition and Cancer в 2010 году, доказывает, что даже 30 минут хватит, чтобы сократить риск рака молочной железы (которому подвержена каждая восьмая женщина в мире) на 35%.5.Как влияет алкоголь на клетки рака?
Поменьше алкоголя! Алкоголь обвиняют в возникновении опухолей полости рта, гортани, печени, прямой кишки и молочных желёз. Этиловый спирт распадается в организме до уксусного альдегида, который затем под действием ферментов переходит в уксусную кислоту. Ацетальдегид же является сильнейшим канцерогеном. Особенно же вреден алкоголь женщинам, так как он стимулирует выработку эстрогенов — гормонов, влияющих на рост тканей молочной железы. Избыток эстрогенов ведёт к образованию опухолей груди, а значит, каждый лишний глоток спиртного увеличивает риск заболеть.6.Какая капуста помогает бороться с раком?
Полюбите капусту брокколи. Овощи не только входят в здоровую диету, они ещё и помогают бороться с раком. В том числе поэтому рекомендации по здоровому питанию содержат правило: половину дневного рациона должны составлять овощи и фрукты. Особенно полезны овощи, относящиеся к крестоцветным, в которых содержатся глюкозинолаты — вещества, которые при переработке обретают противораковые свойства. К этим овощам относится капуста: обычная белокочанная, брюссельская и брокколи.7.На заболевание раком какого органа влияет красное мясо?
Чем больше едите овощей, тем меньше кладите в тарелку красного мяса. Исследования подтвердили, что у людей, съедающих больше 500 г красного мяса в неделю, выше риск заболеть раком прямой кишки.8.Какие средства из предложенных защищают от рака кожи?
Крем нужно выбирать с фактором защиты SPF 15, наносить его даже зимой и даже в пасмурную погоду (процедура должна превратиться в такую же привычку, как чистка зубов), а также не подставляться под солнечные лучи с 10 до 16 часов.
Запаситесь солнцезащитными средствами! Женщины в возрасте 18–36 лет особенно подвержены меланоме, самой опасной из форм рака кожи. В России только за 10 лет заболеваемость меланомой выросла на 26%, мировая статистика показывает ещё больший прирост. В этом обвиняют и оборудование для искусственного загара, и солнечные лучи. Опасность можно свести к минимуму с помощью простого тюбика солнцезащитного средства. Исследование издания Journal of Clinical Oncology 2010 года подтвердило, что люди, регулярно наносящие специальный крем, болеют меланомой в два раза меньше, чем те, кто пренебрегает такой косметикой.9.Как вы думаете, влияют ли стрессы на развитие рака?
Сам по себе стресс рака не вызывает, но он ослабляет весь организм и создаёт условия для развития этой болезни. Исследования показали, что постоянное беспокойство изменяет активность иммунных клеток, отвечающих за включение механизма «бей и беги». В результате в крови постоянно циркулирует большое количество кортизола, моноцитов и нейтрофилов, которые отвечают за воспалительные процессы. А как уже упоминалось, хронические воспалительные процессы могут привести к образованию раковых клеток.СПАСИБО ЗА УДЕЛЕННОЕ ВРЕМЯ! ЕСЛИ ИНФОРМАЦИЯ БЫЛА НУЖНОЙ, ВЫ МОЖЕТЕ ОСТАВИТЬ ОТЗЫВ В КОММЕНТАРИЯХ В КОНЦЕ СТАТЬИ! БУДЕМ ВАМ БЛАГОДАРНЫ!
- С ответом
- С отметкой о просмотре
Поделитесь с друзьями:
propishevarenie.ru
Прободная язва. Причины, симптомы и лечение пробной язвы
1.Общие сведения
Язва – длительно не заживающая воспаленно-раневая поверхность на эпидермальной (внешней, кожной) или слизистой оболочке. Следует сразу уточнить, что часто смешиваемые, а то и употребляемые в качестве синонимов понятия «язва» и «эрозия» – это не одно и то же. В отличие от эрозии или поверхностной царапины, язва проникает в глубинные, базовые слои разъедаемой поверхности, что приводит к необратимой утрате того или иного объема ткани, а следовательно, и к потерям в ее функциональности. Заживление язв происходит путем частичного или полного замещения дефекта соединительной тканью («зарубцевавшаяся язва»).
Старинный русский глагол «прободить» означает проделать отверстие, прорвать, пробить, проколоть; такое же значение у латинского слова «перфорировать», которое имеет множество производных как в мире техники, так и в медицине.
Таким образом, прободная (перфоративная) язва – это язва насквозь, язва с нарушением герметичности и образованием «пробоины». Термин «прободная язва» употребляется только в гастроэнтерологии и подразумевает агрессивную язву желудка или двенадцатиперстной кишки, – истончаясь, их стенки могут в конце концов прорваться; в каждом десятом случае излияние содержимого в брюшную полость сопровождается также массивным кровотечением. В целом, перфорация гастродуоденальной язвы является одним из наиболее опасных и тяжелых исходов язвенной болезни, создающих непосредственную угрозу для жизни пациента.
Учитывая распространенность язвенно-воспалительных заболеваний ЖКТ (в одной лишь России ими страдает несколько миллионов человек), не приходится долго говорить об остроте и актуальности проблемы прободной язвы. На сегодняшний день одной из главных задач гастроэнтерологии остается разработка не столько диагностических и экстренно-хирургических протоколов (см.ниже), сколько методов точной оценки типа течения и динамики язвенной болезни, а также достоверного прогнозирования и надежного предотвращения прободных ее вариантов.
Обязательно для ознакомления!
Помощь в лечении и госпитализации!
2.Причины
При язвенной болезни желудка и/или двенадцатиперстной кишки чаще всего отмечается определенная сезонная зависимость, и большинство прободений приходится на весну/осень. Известно также, что случаи прободной язвы значительно учащаются в периоды социально-экономических потрясений и военных действий. Вообще, недостаточное и нездоровое питание, особенно в сочетании с хроническим стрессовым напряжением, является одним из главных триггеров (пусковых факторов) язвенной перфорации. Прямой и четкой зависимости от возраста нет, среди пациентов встречаются и дети, и очень пожилые люди, однако статистически наиболее рискованным принято считать возрастной интервал 25-50 лет.
К основным факторам риска относится все, что резко и быстро (или одномоментно) поднимает давление внутри желудка: тупая абдоминальная травма, переедание, физическая нагрузка, употребление спиртных напитков (особенно шипучих).
Посетите нашу страницу
Гастроэнтерология
3.Симптомы и диагностика
В клинике прободной язвы выделяют три этапа, названия которых говорят сами за себя:
- абдоминальный шок;
- мнимое благополучие;
- гнойный разлитой перитонит.
Каждая из этих фаз занимает, в среднем, около шести часов.
Наиболее характерный симптом начального этапа – это резкая и очень интенсивная боль, часто с иррадиацией в соседние зоны или спину. Именно к этому типу болевого синдрома относится известное выражение «кинжальная боль», и она, – как и реальный внезапный удар ножом в живот, – сопровождается мощным психоэмоциональным шоком. В большинстве случаев пациент принимает вынужденную эмбриональную или другую подобную позу, старается не шевелиться (вернее, не может), дышит неглубоко и часто, глаза «западают», лицо приобретает землисто-бледный оттенок и характерное неподвижное страдальчески-паническое выражение. Достаточно типичны также брадикардия и снижение АД, обусловленные рефлекторной реакцией на поражение внутрибрюшных тканей и рецепторов излившейся кислотой желудочного сока.
В дальнейшем цвет кожных покровов лица, дыхание, показатели ЧСС и АД несколько нормализуются. На этом этапе, как правило, теряется драгоценное время: нередко у приободрившегося больного приходится буквально выпрашивать согласие на жизнесохраняющую операцию. Субъективное улучшение недаром называют «мнимым благополучием» – на самом деле это уже смертельный риск, поскольку в следующей фазе (неоднократная рвота, дегидратация, резкое утяжеление общего состояния, тахикардия и тахипноэ, значительное вздутие живота) оказывать помощь, даже самую экстренную и квалифицированную, во многих случаях уже слишком поздно.
Диагноз опытный врач уверенно предполагает уже при внешнем осмотре, пальпации и перкуссии: существует ряд достаточно информативных критериев, касающихся мышечного статуса, зон и характера болезненности и пр.
Впрочем, многое зависит от конкретной локализации прободения и динамики симптомов. В некоторых случаях ситуация развивается по атипичному сценарию; в частности, клиническая картина может походить на симптомы острого аппендицита, инфаркта миокарда, легочной патологии, – иными словами, требуется дифференциация и уточнение. Помимо физикального осмотра, назначают лабораторные анализы, рентген-исследование (обычно с контрастным веществом, обнаружение которого за пределами желудка и двенадцатиперстной кишки является стопроцентным доказательством прободения), срочную фиброгастродуоденоскопию. В некоторых диагностически сложных случаях прибегают к лапароскопическому исследованию.
О нашей клинике
м. Чистые пруды
Страница Мединтерком!
4.Лечение
Перфорация язвы – абсолютное и однозначное показание к неотложному хирургическому вмешательству. Применяемые методики (ушивание, резекция и пр.), антисептические меры, стратегия постоперационного лечения и реабилитации – могут быть разными, поскольку характеристики прободной язвы широко варьируют и, кроме того, ключевое значение имеет масштаб и стадия процесса на момент вмешательства.
Важной задачей является профилактика осложнений – пневмонии, гнойных воспалений, нарушений перистальтики и т.п.
Остается добавить, что даже неизменное мастерство отечественной школы неотложной хирургии (а о том, что ради спасения жизни пациента в операционной иной раз приходится совершать истинное чудо, по-настоящему знают только сами хирурги), прободная язва характеризуется значительным процентом летальности (на сегодняшний день это 6-8%). Прогноз в решающей степени зависит от своевременности обращения за помощью и ее оказания, от точности диагностики и выбора оптимального плана операции.
medintercom.ru
симптомы и лечение, причины возникновения, оказание неотложной помощи
Язвенная болезнь желудка возникает при деструктивных изменениях в слизистой оболочке органа, когда снижается его защитная функция. Это приводит к увеличению патологического очага и без терапии полностью разрушает желудочную стенку. Когда под действием физического, бактериального или химического раздражителя возникает просвет в стенке желудка – развивается прободная язва, которая может привести к летальному исходу.
Причины возникновения прободной язвы и факторы риска
Прободение язвы желудка или двенадцатиперстной кишки – это хроническое заболевание, возникающее при осложнении хронического заболевания этих органов. Провоцирующим фактором могут стать следующие моменты:
- Наполнение повышенным объемом пищи желудка.
- Обострение хронической язвы.
- Резкая физическая нагрузка.
- Прием алкоголя, жирная или острая пища.
- Усиленная кислотность желудка.

Все эти причины прободной язвы желудка действительны при наличии язвенной болезни, возбудителем которой является бактерия Helicobacterpylori. Хотя этим микроорганизмом заражено 50 % населения Земли, болеют не все. Активизирует патогенное влияние бактерии любое нарушение защитных функций нашего организма. К факторам риска возникновения язвенной болезни относят:
- нарушение качества сна;
- длительный стресс;
- понижение иммунитета;
- бесконтрольный прием НПВП;
- курение;
- потребление алкоголя;
- нарушение качества питания;
- наличие гастрита или других патологий ЖКТ;
- наследственность.
Симптомы и признаки заболевания
Лечение прободной язвы желудка (код по МБК 10) зависит от стадии воспалительного процесса. Провоцируется болезнь от попадания в брюшную область содержимого желудка. Далее начинается первый период развития прободной язвы – химический перитонит. Длится он от 3 до 6 часов, сопровождаясь острой болью в правом подреберье или околопупочном сегменте, позже охватывая всю область живота. У больного повышается потоотделение, кожа бледнеет, артериальное давление снижается, дыхание становится учащенным, иногда появляется рвота, желудочно-кишечное кровотечение.

При отсутствии лечения спустя 6 часов проявляется бактериальный перитонит, когда резкие боли исчезают. На этой фазе повышается температура, учащается пульс, нарастает интоксикация организма. Больной начинает испытывать облегчение, становится некритичным к своему состоянию. Если в этот период помощь не будет оказана, то пациент переходит к самой тяжелой стадии прободной язвы.
Период острой интоксикации начинается по истечении 12 часов с начала болезни и характеризуется постоянной рвотой, которая быстро приводит организм к обезвоживанию. Характерные симптомы прободной язвы 3 этапа: кожные покровы становятся сухими, повышенная температура тела понижается до 36 градусов, артериальное давление снижается ниже нормы, процесс мочевыделения прекращается, замедляется реакция пациента на внешние раздражители. Больному, достигшему этой фазы жизнь спасти уже невозможно.
Классификация прободной язвы
Прободная язва двенадцатиперстной кишки и желудка классифицируется по клиническому протеканию болезни, по локализации очага (желудок или 12 перстная кишка) и по патолого-анатомическим признакам. Протекает заболевание в двух формах: типичной, когда содержимое желудка попадает в брюшную область и атипичной, когда содержимое попадает в сальниковую сумку или вытекает в забрюшинную клетчатку.
Патолого-анатомические признаки прободной язвы:
- Прободение острой язвы.
- Осложнение хронической болезни желудка.
- Перфорация при заражении паразитами.
- Прободение при поражении желудка опухолевым образованием.
- Нарушенное кровообращение.
Диагностика
Начинается диагностика с тщательного опроса жалоб пациента, изучения истории болезни, физических и лабораторных исследований, использования рентгеновского и эндоскопического метода. Для прободной (перфоративной) язвы характерен болевой приступ, поэтому первое, к чему прибегает врач – это осмотр с применением пальпации на левом боку и рентген. С помощью основного рентгенологического метода определяется наличие сквозного дефекта, воздуха в брюшной полости под диафрагмой и завоздушенность кишечника, характерное для прободной язвы.
Дополнительные методы исследования для уточнения диагноза:
- Эндоскопия. Проводится, если есть подозрение прободной язвы, а рентгенологическое исследование дало отрицательный результат.
- Электрокардиограмма. Делается для оценки сердечной деятельности, наличия рубцов на сердце, определения нарушения ритма. С помощью ЭКГ исключается инфаркт миокарда.
- УЗИ. Подтверждается наличие газов в кишечнике, выявляется очаг поражения стенок желудка и размер окружности прободного отверстия.
- Анализ крови (общий). Показывает наличие повышенного содержания лейкоцитов.
- Лапароскопия. Помогает количественному и качественному анализу накопления выпота в полости живота.
Лечение прободной язвы желудка и двенадцатиперстной кишки
Лечатся прободные язвы только оперативным вмешательством. Предоперационная подготовка к резекции желудка заключается в восстановлении артериального давления и выводе желудочного содержимого. Специалистами учитывается начало приступа по времени, размер и локализация язвы, возраст пациента, наличие других патологий, а потом определяется техника операции.
Оперативное вмешательство при прободной язве бывает двух видов: ушивание, при котором в ходе операции орган сохраняется и резекция – радикальное иссечение язвы, которое ведет к потере большой части желудка, а после пациент получает инвалидность. Ушивание показано при распространенном перитоните, а техника заключается в иссечении края язвы и последующем сшивании части желудка. Резекция делается при наличии больших хронических язв, подозрении на онкологию, гнойном перитоните.

Неотложная помощь при внезапной острой боли
При любом подозрении на приступ прободной язвы больному должна быть оказана первая помощь, которая заключается в срочной его доставке в стационар. Точный анамнез болезни сможет составить только квалифицированный врач, и чем раньше это случится, тем лучше. Не надо думать, что неотложная помощь при прободной язве желудка – это прием наркотических анальгетиков, поскольку эти препараты только загладят симптомы, что дезориентирует доктора и помешает в правильной организации сестринского процесса.
Диета после операции прободной язвы
Питание в период восстановления после иссечения прободной язвы играет очень важную роль. Диета направлена на восстановление перистальтических и секреторных функций, поэтому рацион должен быть полноценным и сбалансированным. Он должен состоять их ежедневных углеводов (420 г), жиров (100 г), белков (100 г). Можно кушать соль не более 12 г/день, а воды выпивать не менее 1,5 литра/день. Калорийность ежедневного меню не должна быть выше 3000 ккал.
Питание после операции должно происходить дробно по 5-6 раз/день и мелкими порциями. Перерыв между приемами пищи не следует делать больше 4 часов. Что касается запрещенных продуктов, то не стоит включать в рацион сдобную выпечку, грубомолотый хлеб и любые свежеиспеченные изделия. Придется отказаться от грибных и мясных бульонов, жирного мяса, жареных блюд, копченостей, консервации и кисломолочных продуктов.
Запрещенные продукты после операции прободной язвы: яйца вкрутую, кукуруза, бобы, пшено, перловка, капуста, редис, шпинат, огурцы, грибы, приправы, острые закуски, квас, кофе, газированная вода, алкоголь.
Что можно есть: примерное меню на день
Несмотря на множественные запреты, меню после удаления прободной язвы может быть очень разнообразным. Сразу после оперативного вмешательства на 1-2 сутки дают только воду, некрепкий чай. Постепенно вводят протертые супы, каши, овощные пюре.
Если на 10 сутки после операции не тошнит, нет болей, отрыжки и других неприятных признаков, то разрешается применять не протертую еду. Приблизительное меню на день после реабилитации:
- Завтрак — яйцо всмятку, некислый творог, бутерброд с масло, какао.
- Ланч — тыква, запеченная с медом.
- Перекус — сухарик, йогурт.
- Обед — овощной супчик, куриное филе, приготовленное на пару.
- Полдник — отварной рис, паровая котлетка, молочно-ягодный кисель.
- Ужин — запеченная рыба, морковное пюре.
Возможные осложнения заболевания и прогноз
Самое главное последствие прободной язвы – это перитонит. В брюшной полости накапливается содержание желудка, которое вытекло, что провоцирует возникновение гноя. Если вовремя не провести операцию, то человек проживет 2-3 суток. Отсутствие хирургического лечения прободной язвы – 100 % смерть во всех случаях. Послеоперационная летальность составляет 5-8% от возникновения осложнений, возраста и наличия сопутствующих патологий больного.
wjone.ru
Язва желудка Симптомы прободной язвы желудка
Симптомы прободной язвы желудка Рассмотрим, что такое прободная язва желудка, симптомы заболевания и какая должны быть оказана неотложная помощь. Прободение (перфорация) является тяжелым и нередким осложнением язвенной болезни желудка или двенадцатиперстной кишки. Прогрессирующий при этом «прободной» перитонит протекает столь быстро, что запоздалый или неправильный диагноз равноценен смертному приговору с ничтожными шансами на спасение.
Перфорация язв, так же как и их обострение, чаще отмечается в зимне-весеннее время. Прободная язва желудка симптомы. Зачастую за несколько дней до катастрофы им предшествует усиление болей в эпигастрии. Однако в ряде случаев имеющаяся у больных язва протекает бессимптомно («немая язва»), и только внезапно возникшая перфорация служит первым ее проявлением. В некоторых случаях перфорируют так называемые острые язвы, часто развивающиеся у больных, длительно принимавших стероидные гормоны. Все же большинство пациентов имеют длительный язвенный анамнез: боли в эпигастрии в прошлом, изжоги и т. д.
При прободении язвы в свободную брюшную полость клиническая картина яркая, ведущим симптомом является боль, которая появляется внезапно, чрезвычайно интенсивна, напоминает «удар кинжалом в живот». Она значительно сильнее, чем при других абдоминальных катастрофах, вследствие раздражения многочисленных нервных окончаний брюшины кислым желудочным соком. Больные сразу принимают то или иное вынужденное положение (горизонтальное или сидячее), часто с приведенными к животу и согнутыми в коленных суставах ногами и, боясь пошевельнуться, всячески стараются его сохранить.
При перфорации желудочных язв боли обычно локализуются в эпигастральной и околопупочной области, а при перфорации язв двенадцатиперстной кишки – в правом подреберье, а затем соответственно распространению излившейся жидкости по правому боковому каналу – в правой подвздошной области. Однако разграничение болей возможно лишь в первые часы. В дальнейшем боли распространяются и охватывают весь живот. Обычная для большинства абдоминальных катастроф рвота чрезвычайно редко наблюдается при прободных язвах. Часто отмечается френикус-симптом (болезненность при надавливании между ножками грудино-ключично-сосцевидной мышцы). Боли иррадиируют в правое плечо, под правую лопатку, в область правой ключицы, что объясняется раздражением диафрагмальной брюшины, чаще ее правого купола, излившимся желудочным содержимым. Симптомы прободной язвы желудкаВажнейший объективный симптом прободной язвы – наряду с появлением симптомов раздражения брюшины очень резкое напряжение мышц передней брюшной стенки. Ни при одном остром заболевании брюшной полости не наблюдается такого сильного напряжения мышц живота, как при прободной язве, они часто тонически сокращены.
У худых больных обычно вырисовываются обе прямые мышцы живота с характерными поперечными бороздами от сухожильных перемычек. Напряжение мышц характеризуется классическим выражением «доскообразный живот». Этот видимый глазом еще до пальпации живота симптом чрезвычайно характерен для прободения язв и позволяет, как правило, сразу поставить верный диагноз. Следствием резкой ригидности брюшных мышц является отчетливо выраженная «ладьевидная втянутость живота». Нередко больной для уменьшения болей держит туловище согнутым вперед. Напряжение мышц – ранний симптом. Оно ослабевает с развитием перитонита, сменяясь паретическим вздутием кишечника. Выхождение воздуха через перфорационное отверстие, скопление его под диафрагмой обусловливают характерное для прободных язв исчезновение печеночной тупости.
При перкуссии снизу вверх тимпанит над органами живота сразу переходит в легочный звук над правой половиной грудной клетки. Диагностика прободной язвы Клиническая картина прободения язвы в свободную брюшную полость столь характерна, что диагноз обычно не вызывает затруднений. Однако в некоторых случаях (малый диаметр перфорационного отверстия, пустой до перфорации желудок, близость печени или сальника) перфорационное отверстие прикрывается и дальнейшее поступление желудочного содержимого прекращается. «Мнимое благополучие» может быть связано также с разведением соляной кислоты экссудатом и действием эндорфинов. Клинически это проявляется тем, что боли прекращаются, доскообразное разлитое напряжение мышц живота исчезает, и отмечается только небольшой участок напряжения в эпигастральной области и правом подреберье. Все же в большинстве случаев прикрытие оказывается непрочным, а «самоизлечение» только временным, и после короткого перерыва вновь возникает картина перфоративной язвы с развитием перитонита.
Изредка встречаются атипичные перфорации. Их атипичность состоит в том, что прободение язвы наступает не в свободную брюшную полость, а в забрюшинную клетчатку или между листками малого сальника. Заболевание также развивается остро, однако боли бывают выраженными не столь резко, отсутствует доскообразное напряжение мышц. Поступление воздуха через перфорационное отверстие в забрюшинную клетчатку и дальнейшее его распространение вызывают появление подкожной эмфиземы на передней брюшной стенке, шее, мошонке. В дальнейшем клиническая картина развивается по типу септицемии, забрюшинной флегмоны. Распознавание атипичных перфораций чрезвычайно затруднено. Как правило, поздно диагностируются и перфорации кровоточащих язв, но подобное сочетание тяжелых осложнений язвенной болезни встречается редко.
Перфорация, осложняющая язвенное кровотечение, у ослабленного, анемизированного и ареактивного больного протекает обычно скрыто, иногда проявляясь лишь усилением болей и легкой мышечной защитой в эпигастральной области. Наконец, диагностика перфорации язвы может представлять сложности у пациентов, находящихся в состоянии алкогольного опьянения. Таким образом, внезапное появление резчайших болей в животе, сопровождающихся доскообразным напряжением мышц передней брюшной стенки и вынужденным неподвижным состоянием больного, служит основанием для диагностики прободной язвы. Лабораторные показатели могут быть в пределах нормы, высокий лейкоцитоз и сдвиг формулы влево появляются только на стадии развития перитонита.
При рентгенологическом исследовании выявляется характерное скопление воздуха в виде «серпа», чаще под правым, реже – под обоими куполами диафрагмы. Установление диагноза перфоративной язвы или подозрение на нее диктуют необходимость экстренной госпитализации больного и незамедлительной операции при подтверждении диагноза. Столь же настоятельны показания к госпитализации и операции у больных с прикрытым прободением, несмотря на стихание болей и хорошее общее состояние. В тех случаях, когда ни госпитализация больного, ни экстренная операция на месте невозможны (например, в условиях бездорожья и нелетной погоды), целесообразны постоянная аспирация желудочного содержимого с помощью желудочного зонда, введенного через нос, и инъекция атропина для уменьшения секреции.
s-sonnik.ru
Симптомы прободной язвы желудка

Перфорация, или прободная язва желудка, – острое критическое состояние язвенной болезни желудка и двенадцатиперстной кишки, выражающееся образованием прободения с выходом в брюшную полость или за брюшину.
Исследовательская статистика показала, что у больных с длительным язвенным анамнезом перфорация желудка встречается довольно часто. Прободение обычно наступает у мужчин молодого и среднего возраста и пожилых лиц.
Опасность перфорации желудка заключается в том, что при прободении стенки возникающий перитонит прогрессирует стремительно. Неправильный или несвоевременно поставленный диагноз шансов на спасание больного практически не оставляет. Поэтому чрезвычайно важно обратить внимание на признаки этой грозной болезни.
Симптомы прободной язвы желудка

Обострение этой болезни происходит, как правило, в зимний период и весеннее время. Признаками приближающейся катастрофы является интенсивно развивающаяся боль в подреберье с правой стороны и области эпигастрия. Однако коварство этой болезни в том, что она может протекать без соответствующих характерных признаков, и только острая и внезапно возникшая боль может свидетельствовать о перфорации стенки желудка. Но в большинстве случаев прободению желудка предшествует длительный анамнез с определенными симптомами в виде боли в эпигастрии, изжоги, тошноты и т.п. У людей, длительное время принимающих стероидные гормональные препараты часто развивается перфорацией язвы желудка.
Главным симптомом, свидетельствующим об обострении язвы, является появившаяся внезапно резкая боль, которая нарастает интенсивно и напоминает острый удар колюще-режущим предметом. Боль распространяется быстро по всему животу и первоначальная локализация ее уже не ощущается. У пострадавшего в течение нескольких из-за очень сильной боли может быть шоковое состояние, возникать тошнота и рвота вместе со сгустками крови.
Предельное мышечное напряжение стенки брюшной полости позволяет сделать объективный вывод о наличии прободной язвы желудка. При иных видах острых заболеваниях мышцы обычно приходят в повышенный тонус, но не настолько резко, как в случае перфорации желудка. «Доскообразный живот» у больного позволяет безошибочно диагностировать перфорацию язвы желудка.
Характерный дегтеобразный черного цвета стул больного свидетельствует об открывшемся кровотечении в двенадцатиперстной кишке. Больной чувствует шум в ушах, слабость, головокружение, озноб, что может привести к потере сознания.
Важно обратить внимание на признаки возможного развития перитонита при перфорации желудка. К таким признакам относятся: повышение температуры, сердцебиение, эйфория, сухость во рту.
Симптомы перфорации язвы желудка настолько характерны, что диагностика заболевания обычно не вызывает затруднений. Однако при незначительном сквозном отверстии в стенке желудка, возникшем при прободении, перфорационное отверстие прикрывается, и поступление желудочного сока в брюшную полость прекращается. В этом случае клиническая картина не такая четкая.
При всех подозрениях на эту опасную болезнь показана незамедлительная госпитализация больного.
Что делать, если отсутствует возможность экспертной госпитализации при перфорации язвы желудка
Если госпитализация больного и проведение экстренной операции невозможны, например, в ситуации бездорожья, недоступности транспортных средств, до эвакуации больного и для спасения его жизни необходимо провести следующие процедуры: ввести в нос больного желудочный зонд для аспирации содержимого желудка, сделать инъекцию атропина для снижения секреторной функции желудка.
Читайте также:
lechenieved.ru
